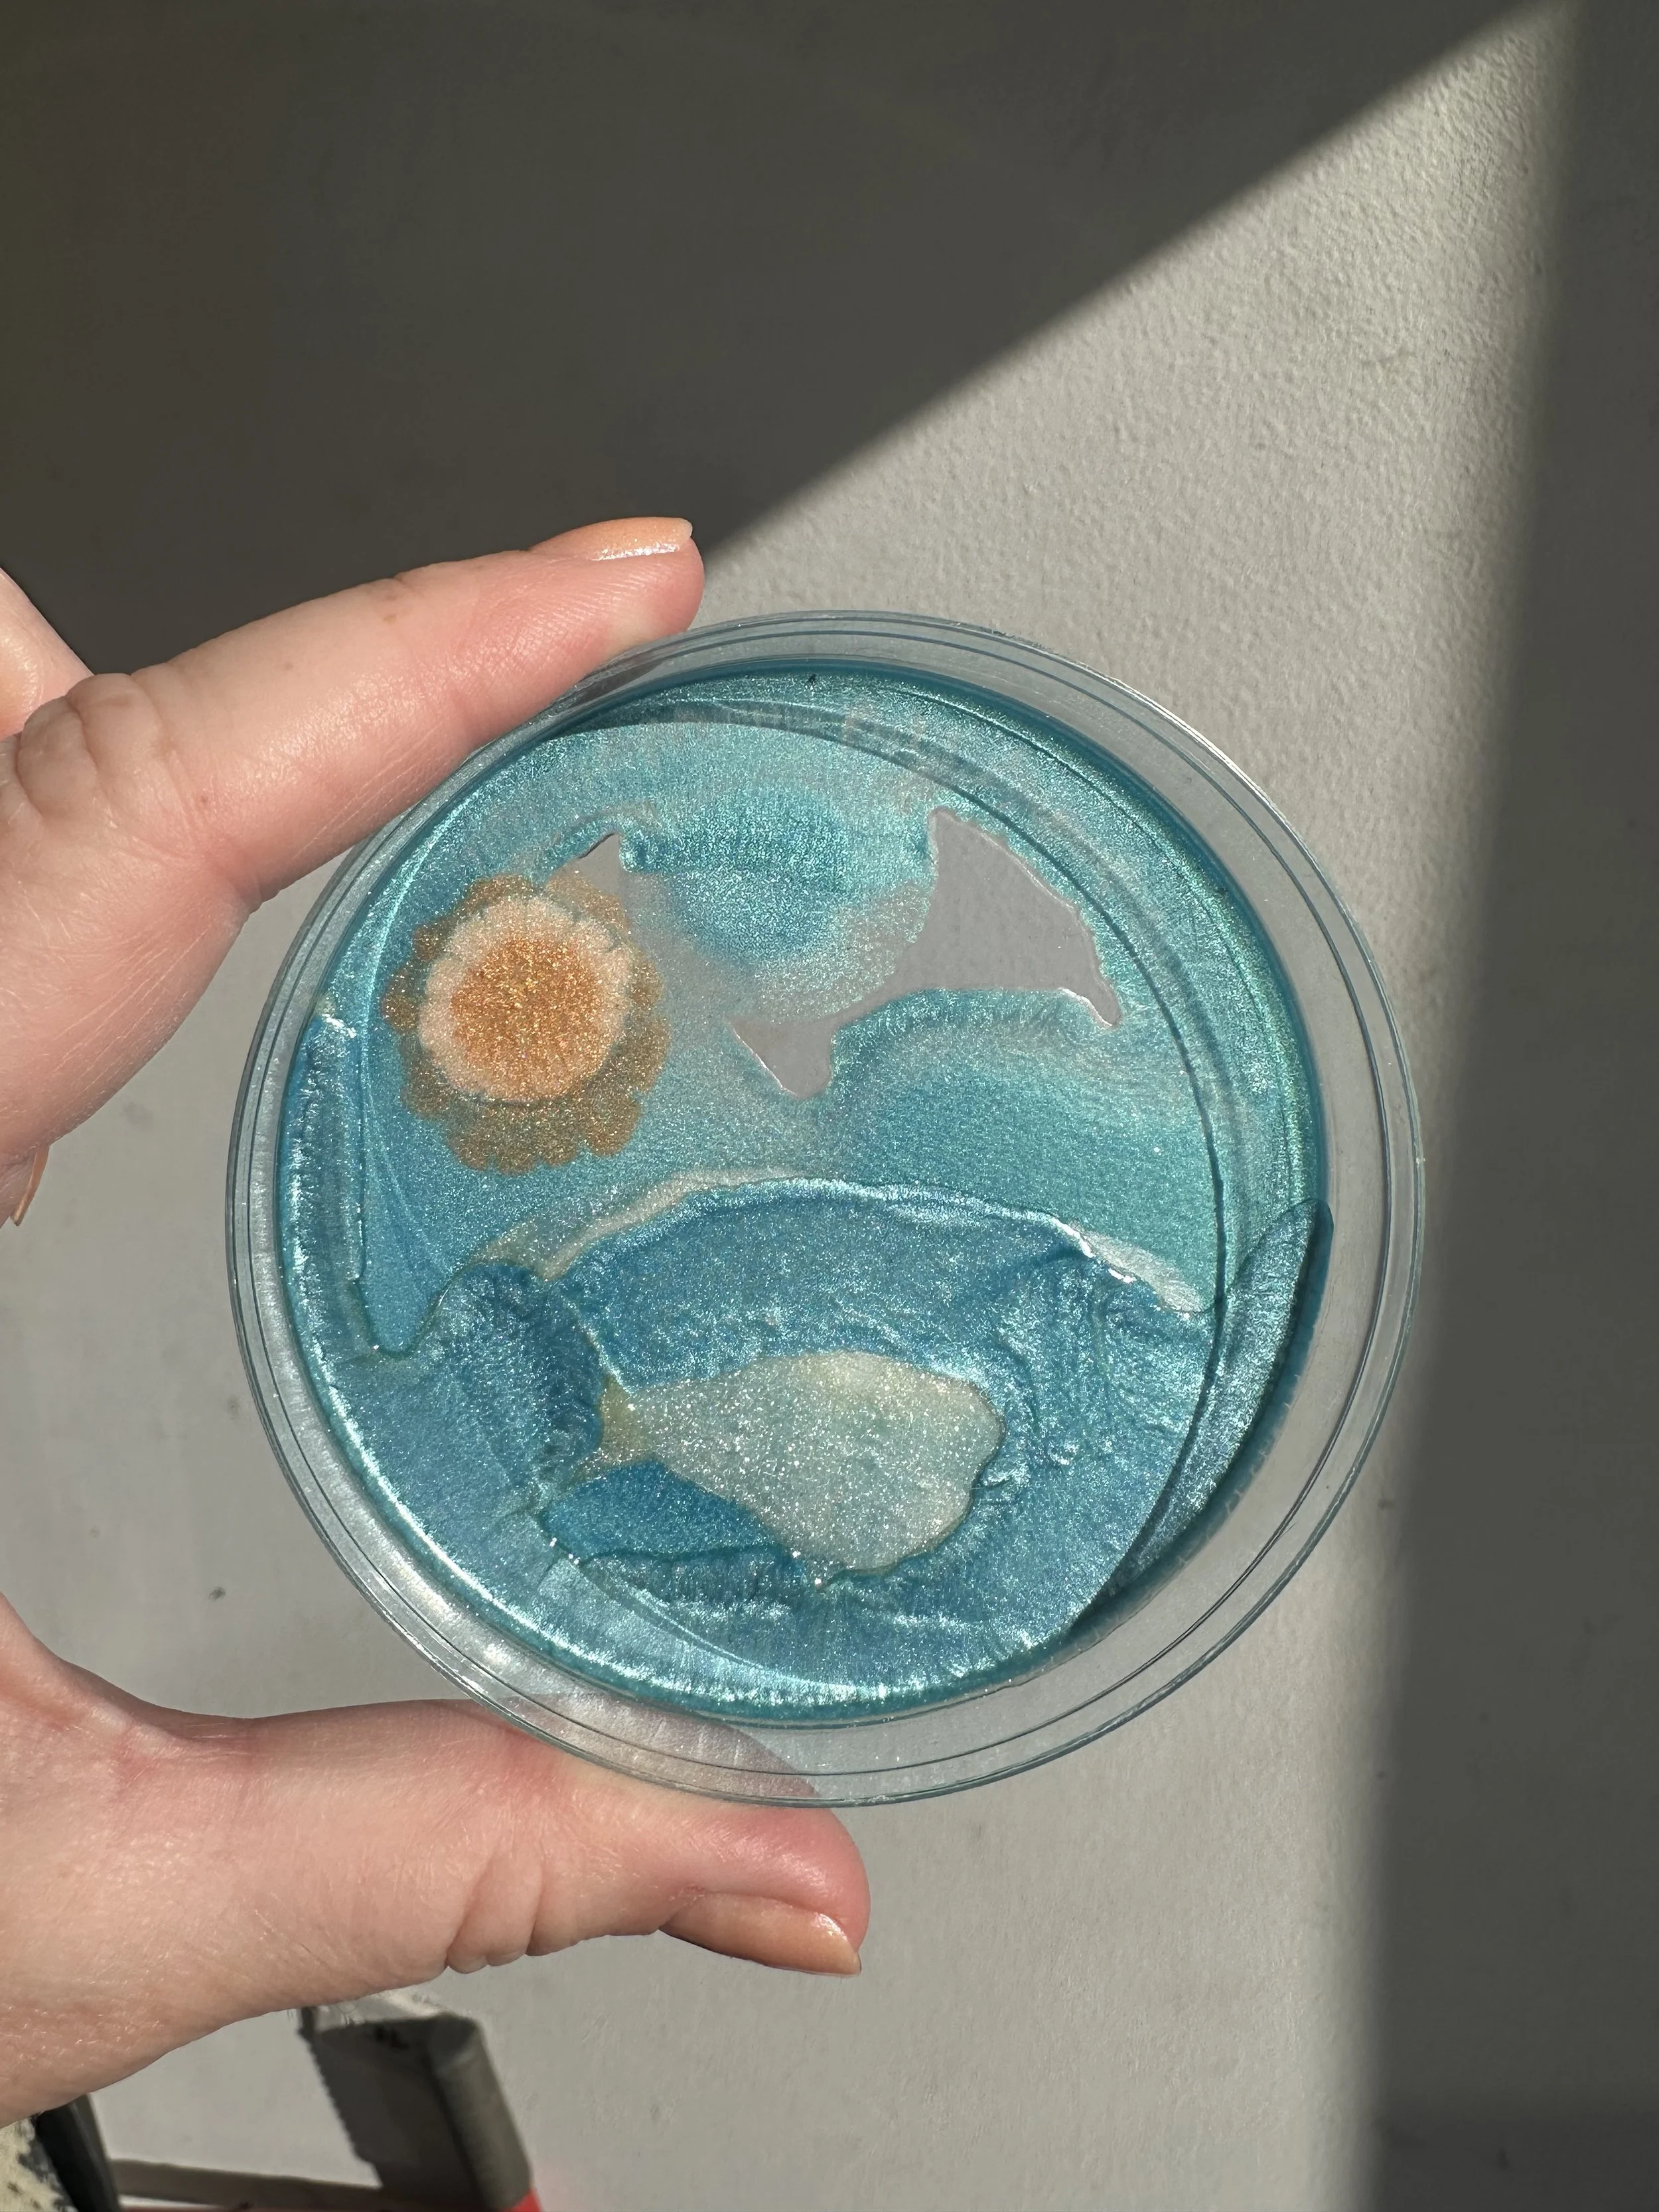
SARAH_ROSE_KELLEY_CARMELBYTHESEA2 - Sarah Rose Kelley.jpeg

VIEW ONSITE: MARCH 14 - MARCH 27, 2026
ONLINE: MARCH 8 - APRIL 30, 2026
participating artists
Abigail Svitko, Adrienne Kinsella, Ahrong Ferreira, Aimee Mandala, AlaÏa Parhizi, Amanda Luce, Amanda Oleander, Amanda Reeves, Amy Armstrong, Amy Mandala, Amy Smith, Andrew Fudge, Andy England, Anjalé Perrault, Anna Wingfield, Annalise Neil, Ariel Cohen, Bad Talents, Betsy E Kendrick, Bob Boyle, Brittany Van Ness, CAL, Cari Jean, Carlos Huizar, Carlos Rittner, Caroline Stoughton, Cecile, Chantée Benefield, Chris Fraticelli, Christine E. White, Constance Brantley, Cynthia Flores, Dakota Noot, Dana Ellis, Danielle Rante, Desert Moonrise, Duncan Sherwood-Forbes, Edward L. Rubin, Elizabeth Souza, Elizabeth W Marshall, Ellen French, Emily Araújo, Erwin Glaub, Fernando Reyes, Glen Wilbert, GReg O, Grudinita, Heawon Yi, Izinfinite, Jade Wolf, James Wilson, Jason Thompson, Jenn Lima, Jessica Wilcox, Jill Robinson, Joaquin Stacey-Calle, Joanna Garel, Jody Zellen, John Dewey, John Q McDonald, Jon Over, JR Berry, Julianne Wallace Sterlin, Julie Drane, Jyll Ethier-Mullen, Kasia Ekstrand, Kathryn Whitten, Katie Steward, Kelley Berg, Kevin Perrault, Kim Farbota, Kimberly Magana, Kris klara, Laura Green, Lauren Evans, Laurie Plevin, Lena Rudnick, Lenny Gerard, Lezlie Kussin, Lili White, Lois Keller, Loren Philip, Loretta Bozung, Lori Michelon, Lucia Znamirowski, Marianna Baker, Marinés Adrianza, Mark X Farina, Mary Lai, Matthew Carter, Meghan DeRoma, Melanie McCarthy, Meritxell Claverol, Michael Singh, Michelle Ramin, Miriam W Schulman, Moira Donovan, Monica Echeverri, Nancy Jo Haselbacher, Naranji JReams, Natasha Olesen, Nefertara, NOCARO, Oana Gamlowski, Oxana Akopov, Rachel Dawson, Reniel Del Rosario, Richard Michael Conti, Rob Homsy, Robert Wynne, Rotem Reshef, Sarah Chalek, Sarah Rose Kelley, Sara Mehrinfar, Sarika Seth, Silvia Wagensberg, Simone Quiles, Spooky Harris, Steve Seagren, Sung-Hee Son, Susan Slater, Tania Cho, Tricia Buchanan-Benson, Vega, Vera Fainshtein, Wenpei Zhang, Wil Spaniol, Wino-strut, XiaoXiao Wu, Yoon Chang, and more….
Dana Ellis, I Was Given, ,Acrylic on masonite, 48"x32", $4000
John Dewey, The Ghosts of the Owen's Valley, oil on canvas, 75 x 140 x 2.5", $20,000
John Dewey, Nocturne, oil on canvas, 46 x 46 x 2.5 in., $6000
Adrienne Kinsella, If I Told You (In Progress), Oil on canvas, 8 x 8 in., $500
Adrienne Kinsella, The Way That I Take, Oil on canvas, 12 x 12 in., $700
Oana Gamlowski, Social Hour Silhouettes, Oil on Canvas, 12'' x 9'' x 0.2'', $349
Kris klara, ‘Chavela’, Oil Paint, Oil Pastel, Charcoal, Acrylic, Graphite and House Paint on Stretched Canvas, 60" x 36", $3000
Kris klara, 99 cent special, Oil Paint, Graphite, Acrylic and Oil Pastel on Wood Panel, 10" x 10", $375
Kris klara, Television Personalities No. 1, 57" x 10" x 1.75", $1950
Meritxell Claverol, Fruit bowl with rims and irregular handles, Paper pulp, concrete, sustainable materials, acrylic paint., 21 x 13 x 18 in., $1350
Meritxell Claverol, Vessel 5.9, Paper pulp, concrete, sustainable materials, acrylic paint., 23x11x11 in., $4900
Meritxell Claverol, Vessel 5.10, Paper pulp, concrete, sustainable materials, acrylic paint., 23x10x10 in., $3900
Amanda Reeves, Magic tricks, Acrylic on canvas, 12.5 x 12.5 x 1.5” (framed), $1800
Duncan Sherwood-Forbes, Folded, , Powder Coated Steel, 18”X25”x3”, $900
Amanda Reeves, Self organize , Acrylic on canvas, 18.5 x 18.5 x 1.5” (framed), $3000
Reniel Del Rosario, Charles Shaw (Capped), Glazed stoneware, 13.5 x 4.5 x 4.5 in., $750
Reniel Del Rosario, Decoy (Capped), Glazed stoneware, 12 x 5 x 5 in., $750
Reniel Del Rosario, Dom Perignon (Corked), Glazed stoneware, 12 x 5 x 5 in., $750
Reniel Del Rosario, Josh (Capped), Glazed 13 x 4.5 x 4.5 in., $750
Reniel Del Rosario, Korbel (Popped), Glazed stoneware, 12 x 5 x 5 in., $750
Reniel Del Rosario, Screaming Eagle (Corked), Glazed, 13.5 x 4.5 x 4.5in., $750
Glen Wilbert, Lifeguard Camp, Huntington Beach, Photography, 20x16 in., $600
Yoon Chang, Chandelier Study, Mixed media on canvas, 16 x 12 x 1.5 in., $800
Brittany Van Ness, Fried Egg, Ceramic, 24 x 24 in., NFS
Yoon Chang, Endless Summer, Acrylic on canvas, 30 x 24 x 1.5", $2500
Jessica Wilcox, Horse Trip 1, Colored pencil on paper, 12 x 9 in, $185
Jessica Wilcox, Horse Trip 2, Colored pencil on paper, 12 x 9 in, $185
Jessica Wilcox, Horse Trip 3, Colored pencil on paper, 12 x 9 in, $185
Bad Talents, Mulholland Blue, Oil on panel, 16x12 in., $625
Bad Talents, Poppies, Oil on canvas, 16x12 in., $325
Andrew Fudge, 18825 Crenshaw Blvd, Acrylic Paint, Foam Board, Paper, Polyethylene, PVA Glue, 3.5 x 3 x 5 in., $188.25
Andy England, No Access, Acrylic on canvas, 24"x18"x2", $1000
Andrew Fudge, 405 Freeway Over Century Blvd. in Z Scale, Acrylic Paint, Foam Board, Paper, Polyethylene, PVA Glue, 11.75 x 23 x 2.5 ., $405
Annalise Neil, Gravity, Bleached and toned cyanotype, watercolor, flashe, kiln-cast glass, handmade wood panel, bronze, 16"H x 8"W x 3.5"D, $6800
Annalise Neil, Loophole, Bleached and toned cyanotype, watercolor, flashe, kiln-cast glass, handmade wood panel, bronze, 16"H x 8"W x 3.5"D, $6800
Rachel Dawson, Energy Cleanse #2, Acrylic & oil on canvas wrapped wood panel, 20" x 16" x 2", $1550
John Dewey, The Ghosts of the Owen's Valley, oil on canvas, 96 x 72 x 2.5", $15,000
Anjalé Perrault, Surf Cowboy Tan, Acrylic and Silkscreen, 12"x12"x1.5", $400
Anjalé Perrault, Surf Cowboy Blush, Acrylic and Silkscreen, 12"x12"x1.5", $400
Anjalé Perrault, Surf Cowboy Yellow, Acrylic and Silkscreen, 12"x12"x1.5", $400
Anjalé Perrault, Surf Cowboy Blue, Acrylic and Silkscreen, 12"x12"x1.5", $400
Rachel Dawson, Thought Forms, Acrylic & oil on canvas, 48" x 36" x 2", $3600
Caroline Stoughton, A Perfect Place, Acrylic on canvas, 5 x 5.5 x 3 in., $250
NOCARO, Hollows, Ceramic, 14x7x6 in., $360
NOCARO, LA Wild, Ceramic, 13x4.5x4.5 in., $200
NOCARO, Ripples, Ceramic, 15x5.5x5 in., $360
Amanda Oleander, Leg Licks, oil on canvas, $3400
Vega, California Dreamweaver, watercolor, ink, and acylic on canvas, 20"x24"x1.5", $2400
Izinfinite, Liquid sole, Acrylic on deck, 8in x 30in , $1200
Spooky Harris, House #2, Acrylic, oil stick, graphit, sumi ink, 16 x20 in, $1200
Spooky Harris, Liberty Legs and the Reluctant Owl Fucker, Acrylic, oil stick, graphite and sumi ink on paper, 18x24", $1400
Jason Thompson, Purple Moon, Oil on canvas, 48"x36", $3600
Amy Smith, LAX, Mixed media paper mache and paper pulp sculpture, 10 x 6.5 x 2 in., $525
Amy Smith, Royal, Mixed media paper mache and paper pulp sculpture, 18 x 8 x 3 in., $900
Amy Smith, Unicorn, Mixed media paper pulp, 8”x5”x2", $450
Abigail Svitko, Cactus Garden, Acrylic on canvas, 14 x 11 in., $1200
Vega, Blossoming Cactus Heart, Ceramics, 6"x7"x3", $333
Vega, Chevelle Malibu Sunflower, Ceramics, 4"x7"x2", $333
Bob Boyle, Work Song, ,Acrylic &Spray Paint on Wood, 24 x 24 x 2.25 in., $425
Christine E. White, Devour, oil, 18.75" x 15.75", $1200
Christine E. White, Savor, 18.75" x 15.75", $1200
Cynthia Flores, Rebirth, Digital Photography, Framed 11x14 in., $300
Wino-strut, Every River 001, Oil, House Paint, Acrylic, Pencil On Linen, 16”x 12”, $2000
Wino-strut, Every River 082, Oil, House Paint, Acrylic, Pencil On Linen, 16”x 12”, $2000
Elizabeth W Marshall, Be Hawking Cool, Ceramic and wood, 9 X 7 x 8 in., $250
Emily Araújo, Palm Abstraction, gouache and watercolor on Arches paper, 12" x 9" (work) 16 1/2" x 13 3/8" x 1 1/4"(frame size), $600
Desert Moonrise, Unbound, Unbent, Unbroken, 2025, Acrylic On Canvas, 48 x 36 x 1.5 in $2,600
Carlos Rittner, Llave de Luz, Acrylic box with neon, 12" x 18", $2750
Marianna Baker, Crawled Out, Ceramic + Fiber Art, 16x32x8", $1500
Laurie Plevin, Malibu Lagoon II, Acrylic on canvas, 12” x 16”, $600
Anna Wingfield, Hidden Tennis Courts, Monotype, 11 1/8 x 9 1/8 x 1.25 in., $450
Jill Robinson, The Long Road, stoneware clay, 17 x 5 x 5 in., $300
Jill Robinson, stoneware clay, 12 x 6.5 x 6.5, 13 x 6.5 x 6.5 , 12.5 x 7 x 7 in., $200, $200, $400
Alaia Parhizi, The Prophet that Rebelled against God, Oil Paint on canvas, 20x 24 x 1, $1600
Marinés Adrianza, Florentino, Nylon, wire, fabric, embroidery thread, nails and drifted wood, 36x36x36, $3500
John Q McDonald, Warming Hut, San Francisco, Oil on Canvas, 12x16 in., $750
JR Berry, First Light, Archivel Pigment Print, Acrylic, 16.6 x 11.75 x 5 in., $800
Jyll Ethier-Mullen, Blue into the Blue, Acrylic inks, watercolors, acrylic pen, arches paper collage, with frame 18x24 in., $395
Kasia Ekstrand, Art Deco Eagle, stained glass, 15x8x0.25 in., $800
Katie Steward, What We Called Love, Oil on canvas, 20" x 16" x .5", $800
Kelley Berg, Mister Major, Mixed media, 11x14x1.5 in., $625
Kevin Perrault, Surf 011, copper, stone, & wood, 11” x 11” x 7”, $2000
Kevin Perrault, Tree 001, copper, stone, & wood, 16” x 9” x 6”, $2000
Kimberly Magana, Sandy Day, Oil on canvas, 12 x 12 x 2.5 in., $130
Lauren Evans, Gems 2, Mixed media ceramics, 7 x 13.5 x 1 in., $500
Yoon Chang, The Golden Hour, Oil and oil stick on canvas, 60 x 48 x 2", $10,000
Lena Rudnick, Remains, ,archival digital photography print, 16 x 24 x 2 in., $1100
Lenny Gerard, Food Trucks of Diversity, Gel Transfer, Watercolor, Gouache, Ink, 13x13x2 (framed), $350
Lois Keller, Navigating Los Angeles, pastel and graphite on found paper, Thomas Guide Map of Los Angeles, 9" x 24" x 1" in., $600
Michael Singh, Resistance (III) , Mixed media, 11”x 14” in., $475
Michelle Ramin, Everyone Is Welcome Here (Except I.C.E.), color pencil on paper, 22 x 30 in., $2500
Miriam W Schulman, Love in the Sand, Archive Pigment Print, 20x16 in., $375
Moira Donovan, Sea Stars, acrylic on canvas, 24" x 18" x .5", $350
Monica Echeverri, Summer Haze, Oil on canvas, 5 x 7 x 1 inch (framed), $215
Ariel Cohen, City Bird, City Lights, Acrylic and oil pastel on paper, 14 x 11 x 2 in., $150
Oxana Akopov, Summer Breeze, Pastel on sanded paper, 10" x 18", $750
Richard Michael Conti, Green Cypresses in Movement (edition of 1), 11" x8.5" unframed, 16.75" x 12.75" framed, $250
Robert Wynne, The Mesa Palm Springs, Acrylic on Canvas, 18" x 18", $1500
Laura Green, Wolf in the Snow, acrylic on canvas, 20x20x2 in., $1600
Heawon Yi, , ONENESS-0022(Smile-02), Acrylic and texture paste on wood panel, 22" dia., $4500
Nefertara, California Sunset, Oil on canvas, 14" x 7" x 0.5", $765
Rotem Reshef, Chinatown Retreat #2, Diluted acrilyc and peeled vegetation on canvas, 20 x 16 x 1-1/2 in., $3000
Naranji JReams, Together We Ride, Photography, 20 x 16 in., $600
JM Wilson, Native Fear, Acrylic on Canvas, 30” x 34”, $1500
Sarah Chalek, The Tree Huggers, Watercolor on paper, 20.5" x 24" (framed), $1850
Simone Quiles, I carry the weight of the sea on my back, but I don’t regret it, for I get to hear the voices of the wind throughout my days, oil on canvas, 24x24x1.5", $1250
Mary Lai, Time Capsule: Desert Magic, Acrylic paint & paste of wood in plexi case, $880
Mary Lai, Acrylic paint & paste of wood in plexi case, $880
Mary Lai, Time Capsule: Home Sweet Home, Acrylic paint & paste of wood in plexi case, $880
Sung-Hee Son, Mountain River, mixed media, 24 x 24 in., $1200
Sung-Hee Son, Universal Love, acrylic on canvas, 36 x 36 in, $2400
Silvia Wagensberg, Day Of The Doors, acrylic on vinyl, 24" x 21", $1100
Joanna Garel, Rainbow, mixed media on paper, 35 x 35 in. (framed), $1850
GReg O, California Dreamin' Paths Through the Golden State, 5' x 5' x 2-1/2", $7400
Jon Over, Slum Lord, Acrylic on Canvas, 35.5"x12", $400
Steve Seagren, A Walk In The Waves, acrylic on canvas, 20"x20", $1200
Sue Slater, California Dreaming, Mixed Media, 12 x 8 in., $250
Grudinita, Santa Monica promenade, Oil on canvas, 20"x24x 0.8", $1400
Lezlie Kussin, Welcome to Ojai, Mixed media, 30 x 40 in., $6000
Wenpei Zhang, Golden Hour Joy, Film Photography, 21 x 21 in., inquire
XiaoXiao Wu, Daily Life, Canvas,Cotton,Thread,Photograph, 11" x 11", $550
XiaoXiao Wu, Interior Landscape, Canvas,Cotton,Thread,Photograph, 9" x 6", $350
Jody Zellen, Flames, Gouache on canvas, 12 x 12 in., $800
Jenn Lima, Diablito in the Garden, Clay, glaze, high temp wire, 5.1" H, 6.5" W, 2.6" D, $625
Jenn Lima, DKitsune, Clay, glaze, 3.1"H, 3" W, 2.6" D, $155
Lucia Znamirowski, The Biltmore Hotel, Drawing, 6 x 6 in., $250
Agne Skaringa, Peaceful Garden, Watercolor, 9.5 x 7.5, $700
Aimee Mandala, Take Me to the Disco Derby & Call Me Sally, Graphite, Charcoal and Chalk Pastels, 13" x 14", $800
Amy Armstrong, Californica, Oil on canvas, 20” x 24”, $2700
Betsy E Kendrick, Another Selfie, Clay, 6x3x3”, $350
Cari Jean, Many Moons, Ceramic, 13 x 7 x 4.5 in., $450
carlos huizar, ,Mojave with the In-laws, mixed media collage, 12x18, $1100
Cecile, Thorn Within 1, Acrylic and graphite on canvas, 24 x 20 x .5 in, $800
Tania Cho, Fruit Series - Pineapple With Terrier, Acrylic On Canvas, 24 x 18", $2000
Dakota Noot, My Neighborhood Cats, Archival inkjet print, 11 X 14 in., $800
Chantée Benefield, Before The Fire, Acrylic on canvas, 12x12", $800
Chantée Benefield, After The Fire, Acrylic on canvas, 12x12", $800
Chris Fraticelli, It Was Her Nickname In College, broken ceramics and wood, 13 x 15 x 11", $2500
Constance Brantley, ,The Garden ,acrylic, paper, oil stick on canvas, 16" x 12", $650
Danielle Rante, Desert Mustang XI, Monotype on kitakata paper, 21" x 17" in., $1800
Danielle Rante, Desert Mustang XXI, Monotype on kitakata paper, 21" x 17" in., $1800
Elizabeth Souza, Dreaming of Home, Watercolor, 24 x 17 in., $1500
Julie Drane, poppies in the Canyon, acrylic on canvas, 12 x 12", $225
Cynthia Flores, Rebirth, Digital Photography, Framed 11x14 in., $300
Lori Michelon, Coyote Skull, Mixed Media, 15.5 x 12.5 ", $300
Edward L. Rubin, FIRE, Framed Archival Ink Print, 27" x 35" x 2", $2200
Ellen French, Spring Night, Acrylic paint on Canvas, 16" x 20", $780
Fernando Reyes, Los Angeles Arcangel, pencil on paper, 8.5x11 in., $1200
CAL, Lucky Boy, Acrylic and Oil on canvas, 20x16 in., $250
Kim Farbota, California Über Alles, Human hair and copper wire on wooden frame, 20 x 20", $350
Wil Spaniol, Storage 2 - Echo Park, Acrylic on canvas, 24x18, $800
Loren Philip, Welcome to the Golden State, Mixed media, 16x20 in., $500
Kathryn Whitten, Limantour by Moonlight, Bamboo plywood, 4.5 x 5.5 x 1.5 in., $400
Jade Wolf, Eternal Bloom, Ink, Acrylic, Oil Pastel, Gouache, Bees Wax, 18x18", $600
Julianne Wallace Sterling, Lucky Liquor, graphite and oil on clayboard, 30" x 30", $3000
Loretta Bozung, Beach walk, Mixed recycled soft materials, 13 x 9 x5 in, $865
Loretta Bozung, (Multiple), Maple stick, orange tape and recycled yarn, 13 x 9 x5 in, $385
Melanie McCarthy, Datura x Horse x Mountain, oil on canvas, 11 x 14 x 3/4", $806
Nancy Jo Haselbacher, Town Totem: Desert Wall Spell, collage, 16" x 10.25", $900
Natasha Olesen, California Dreaming, Morning at Santa Monica Beach, Archival Pigment Print, 24 x 24 x 1.5, $900
Sarah Rose Kelley, Beep & Boop, Oil Paint in Petri Dish, 2.5" dia., $130
Sarah Rose Kelley, Carmel by the Sea, Oil Paint in Petri Dish, 3.5" dia., $145
Sarah Rose Kelley, Palm Desert, Oil Paint in Petri Dish, 3.5" dia., $145
Sarika Seth, Currents, Photography - Archival Print on Cotton Rag, 12 x 10 x 2.5 in. framed, $200
Sarika Seth, Palmystery, Photography - Archival Print on Cotton Rag, 12 x 10 x 2.5 in. framed, $150
Sarika Seth, Reverie, Photography - Archival Print on Cotton Rag, 12 x 10 x 2.5 in. framed, $200
Tricia Buchanan-Benson, Vulnerable, Ink on watercolor paper with a burnt edge, 11x14 in., $1000
Vera Fainshtein, California Landscapes Triptych, Monotype, chine colle, 15 in x 36 in., $800
Matthew Carter, Dope Forever, acrylic and gouache on wood paper, 11in x 8.5in, $800
Matthew Carter, The Ambassadors, acrylic and gouache on wood paper, 11in x 8.5in, $800
Amanda Luce, Dreamy Desert Bones, Acrylic on Real cow jawbone, 17" x 16" x 3", $380
Lili White, California Dreamin', video,
Ahrong Ferreira, On the Way Home, Watercolor, Color pencil, Gold paint, Gold and Silver Leaf., 20 × 14 in., $2500
Rob Homsy, Peace (1), Ceramic, 11.5"x 8.75", $1500
Rob Homsy, Peace (2), Ceramic, 11.5"x 8.75", $1500
sara mehrinfar, mended, , wax, asphalt, 8x10x2", $1000
Mark X Farina, Jesus can you see it, Aerosol and water color paper, Bamboo wood frame, 14 x 18", $800


This year’s exhibition is presented in partnership with NOURISH LA, a grassroots organization working to fight hunger and reduce food waste across Los Angeles. By rescuing wholesome food that might otherwise be discarded, they help ensure it reaches Angelenos who need it most—because good food should never go to waste.
As part of Dorado 806 Projects’ ongoing commitment to community engagement, a portion of the gallery’s proceeds from the exhibition will be donated to support NOURISH LA’s work addressing food insecurity across Los Angeles.
FOR INQUIRIES, PLEASE CONTACT AMELIE LAURICE, AL@DORADO806.COM